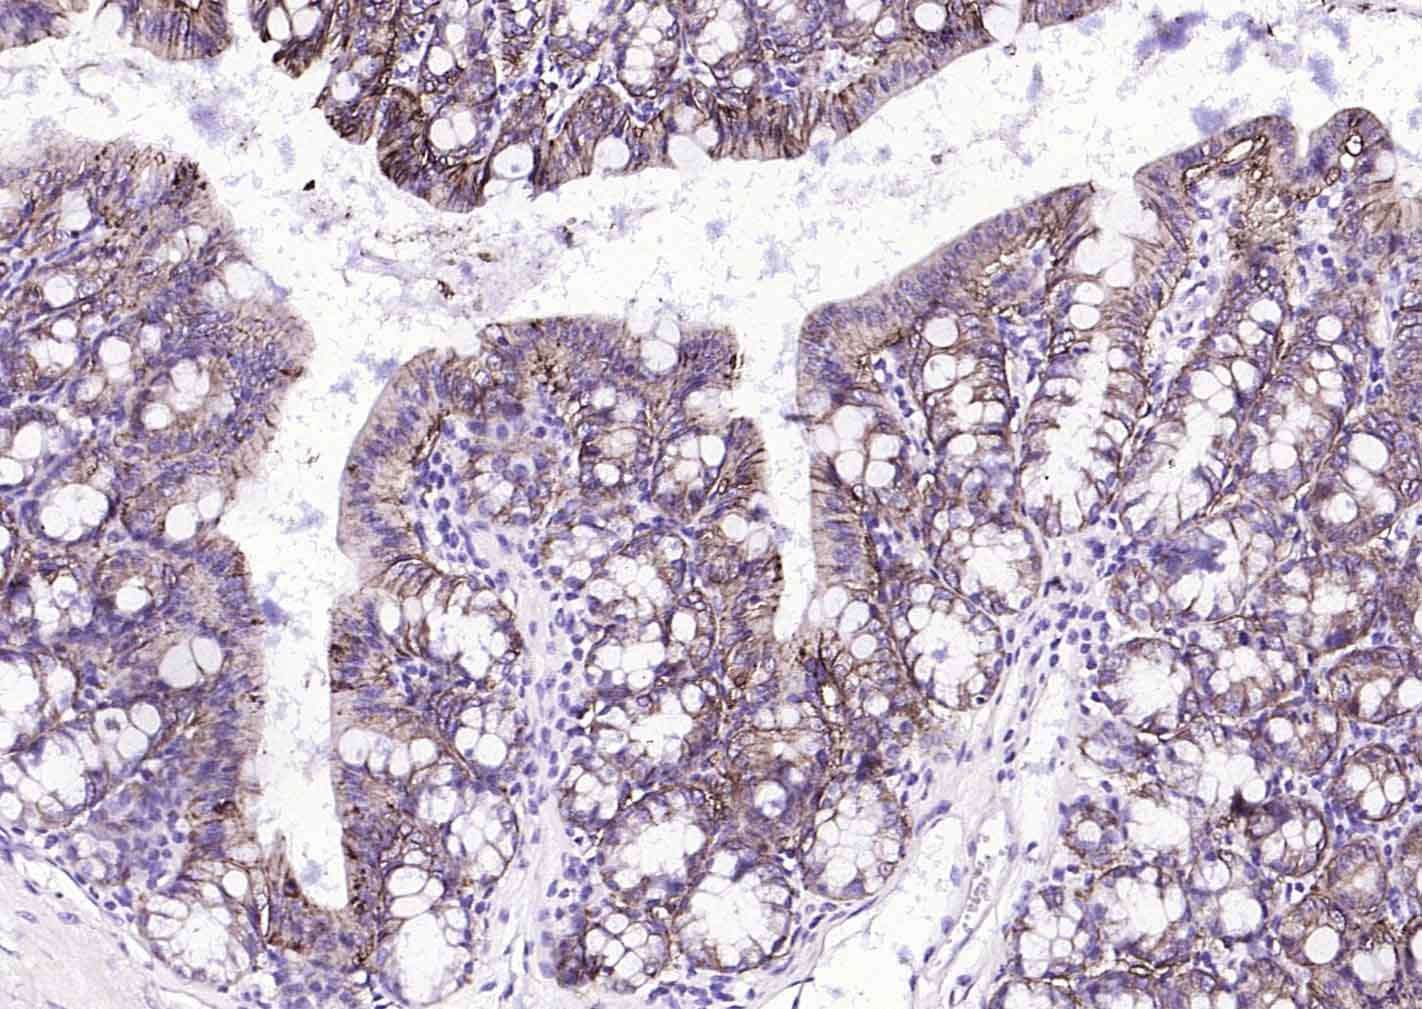
上皮细胞粘附分子（CD326）重组兔单抗

EpCAM Recombinant Rabbit mAb (一抗) - WB,IHC-P,IHC-F,IF | Bioss
Rrmab?兔单抗

货号:bsm-52417R
产品详情
相关标记
相关产品
相关文献
常见问题
概述
产品编号
bsm-52417R
产品类型
重组兔单抗、mIHC精品抗体
英文名称
EpCAM Recombinant Rabbit mAb
中文名称
上皮细胞粘附分子(CD326)重组兔单抗
英文别名
Ber-Ep4; BerEp4; DIAR5; EGP-2; EGP314; EGP40; ESA; HNPCC8; KS1/4; KSA; LYNCH8; M4S1; MIC18; MK-1; MOC-31; TACSTD1; TROP1; CD326; EGP; Ep-CAM; EpCAM1; GA733-2; Ly74; Tacsd1; gp40; EPCAM_HUMAN; EPCAM; Adenocarcinoma-associated antigen; Cell surface glycoprotein Trop-1; Epithelial cell surface antigen; Epithelial glycoprotein (EGP); Epithelial glycoprotein 314 (EGP314 | hEGP314); KS 1/4 antigen; Major gastrointestinal tumor-associated protein GA733-2; Tumor-associated calcium signal transducer 1; M1S2; EPCAM_MOUSE; Epithelial glycoprotein 314 (EGP314 | mEGP314); Protein 289A; EPCAM_RAT; Epithelial glycoprotein 314 (EGP314); Protein D5.7A;
抗体来源
Rabbit
免疫原
A synthesized peptide derived from human EpCAM: 266-314
亚型
IgG
性状
Liquid
纯化方法
affinity purified by Protein A
克隆类型
Recombinant
克隆号
6H5
理论分子量
35 kDa
检测分子量
36 kDa
浓度
1mg/ml
储存液
0.01M TBS (pH7.4) with 1% BSA, 0.02% Proclin300 and 50% Glycerol.
研究领域
SWISS
Gene ID
保存条件
Shipped at 4℃. Store at -20℃ for one year. Avoid repeated freeze/thaw cycles.
注意事项
This product as supplied is intended for research use only, not for use in human, therapeutic or diagnostic applications.
数据库链接
产品介绍
ESA是分子量为35KDa的细胞表面糖蛋白,属广谱的上皮细胞标志物,大多数的上皮细胞均为阳性反应,主要用于各种上皮细胞及其来源的肿瘤的表达。
背景资料
This gene encodes a carcinoma-associated antigen and is a member of a family that includes at least two type I membrane proteins. This antigen is expressed on most normal epithelial cells and gastrointestinal carcinomas and functions as a homotypic calcium-independent cell adhesion molecule. The antigen is being used as a target for immunotherapy treatment of human carcinomas. Mutations in this gene result in congenital tufting enteropathy. [provided by RefSeq, Dec 2008]

产品应用
| 应用 | 已检合格种属 | 预测种属 | 推荐稀释比例 |
|---|---|---|---|
| WB | Human, Mouse, Rat | 1:500-2000 | |
| IHC-P | Human, Mouse, Rat | 1:100-500 | |
| IHC-F | Human, Mouse, Rat | 1:100-500 | |
| IF | Human, Mouse, Rat | 1:100-500 |
交叉反应
交叉反应: Human, Mouse, Rat
相关产品
暂无相关产品
靶标
基因名
EPCAM
蛋白名
Epithelial cell adhesion molecule
亚基
Monomer. Interacts with phosphorylated CLDN7.
亚细胞定位
Lateral cell membrane; Single-pass type I membrane protein. Cell junction, tight junction. Note=Co-localizes with CLDN7 at the lateral cell membrane and tight junction.
组织特异性
Highly and selectively expressed by undifferentiated rather than differentiated embryonic stem cells (ESC). Levels rapidly diminish as soon as ESC's differentiate (at protein levels). Expressed in almost all epithelial cell membranes but not on mesodermal or neural cell membranes. Found on the surface of adenocarcinoma.
翻译后修饰
Hyperglycosylated in carcinoma tissue as compared with autologous normal epithelia. Glycosylation at Asn-198 is crucial for protein stability.
疾病
Defects in EPCAM are the cause of diarrhea type 5 (DIAR5) [MIM:613217]. It is an intractable diarrhea of infancy characterized by villous atrophy and absence of inflammation, with intestinal epithelial cell dysplasia manifesting as focal epithelial tufts in the duodenum and jejunum. Defects in EPCAM are a cause of hereditary non-polyposis colorectal cancer type 8 (HNPCC8) [MIM:613244]. HNPCC is a disease associated with marked increase in cancer susceptibility. It is characterized by a familial predisposition to early-onset colorectal carcinoma (CRC) and extra-colonic tumors of the gastrointestinal, urological and female reproductive tracts. HNPCC is reported to be the most common form of inherited colorectal cancer in the Western world. Clinically, HNPCC is often divided into two subgroups. Type I is characterized by hereditary predisposition to colorectal cancer, a young age of onset, and carcinoma observed in the proximal colon. Type II is characterized by increased risk for cancers in certain tissues such as the uterus, ovary, breast, stomach, small intestine, skin, and larynx in addition to the colon. Diagnosis of classical HNPCC is based on the Amsterdam criteria: 3 or more relatives affected by colorectal cancer, one a first degree relative of the other two; 2 or more generation affected; 1 or more colorectal cancers presenting before 50 years of age; exclusion of hereditary polyposis syndromes. The term 'suspected HNPCC' or 'incomplete HNPCC' can be used to describe families who do not or only partially fulfill the Amsterdam criteria, but in whom a genetic basis for colon cancer is strongly suspected. Note=HNPCC8 results from heterozygous deletion of 3-prime exons of EPCAM and intergenic regions directly upstream of MSH2, resulting in transcriptional read-through and epigenetic silencing of MSH2 in tissues expressing EPCAM.
相似性
Belongs to the EPCAM family.
Contains 1 thyroglobulin type-1 domain.
Contains 1 thyroglobulin type-1 domain.
功能
May act as a physical homophilic interaction molecule between intestinal epithelial cells (IECs) and intraepithelial lymphocytes (IELs) at the mucosal epithelium for providing immunological barrier as a first line of defense against mucosal infection. Plays a role in embryonic stem cells proliferation and differentiation. Up-regulates the expression of FABP5, MYC and cyclins A and E.
同靶标产品
相关文献
提示: 发表研究结果有使用 bsm-52417R 时请让我们知道,以便我们可以引用参考文章。作为回馈,资料提供者将获得我们送上的小礼品。
具体参考文献:bsm-52417R 被引用于1文献中